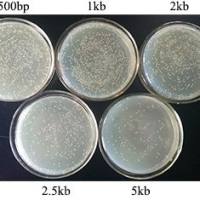
pUC57 Simple TA/平端通用克隆载体

相关产品推荐更多 >
万千商家帮你免费找货
0 人在求购买到急需产品
- 详细信息
- 文献和实验
- 技术资料
- 库存:
大量
- 英文名:
Rosetta (DE3) Chemically Competent Cells
- 保质期:
六个月
- 供应商:
上海信裕生物科技有限公司
- 保存条件:
-80℃恒温保存,避免反复冻融,有效期六个月;干冰运输
- 规格:
100 μl x 5/100 μl x 10
【产品概述】
E. coliRosetta (DE3) 菌株来源于BL21系列宿主菌,其含有pRARE质粒,能够提供AUA,AGG,AGA,CUA,CCC和GGA稀有密码子的tRNA,提高外源基因,尤其是真核基因在原核系统中的表达水平。该质粒具有氯霉素(Camr)抗性。Rosetta (DE3) 菌株基因型为:F-ompThsdSB(rB-, mB-)gal dcm lacY1(DE3)pRARE(argU,argW,ileX,glyT,leuW,proL)(Camr)。本产品是经特殊工艺处理得到的Rosetta (DE3)感受态细胞,可用于DNA 的化学转化。使用pUC19质粒检测,转化效率可达107cfu/ug DNA。
【产品组分】
| 货号 |
XY107-01 |
XY107-02 |
| Rosetta(DE3)Chemically Competent Cells |
5 x 100ml |
10 x 100ml |
| pUC19(0.1 ng/ml) |
10ml |
10ml |
| 产品说明书 |
1份 |
1份 |
【保存条件】
-80℃恒温保存,避免反复冻融,有效期六个月;干冰运输
【注意事项】
1. 融化后的感受态细胞应及时进行转化,以免降低转化效率;融化后再次-80℃冻存的感受态细胞,其转化效率通常降至105cfu/μg DNA以下,仍可进行环形质粒的转化。
2. 整个操作过程要轻柔,避免移液枪吹吸。
3. 请使用传热性能好的薄壁试管或离心管,换用不同的试管或离心管时,应摸索热激时间,以获得最佳转化效率。风险提示:丁香通仅作为第三方平台,为商家信息发布提供平台空间。用户咨询产品时请注意保护个人信息及财产安全,合理判断,谨慎选购商品,商家和用户对交易行为负责。对于医疗器械类产品,请先查证核实企业经营资质和医疗器械产品注册证情况。
文献和实验Transforming chemically competent cells
Method Thaw TSS cells on ice. Add DNA, pipette gently to mix (1μl of prepped plasmid is more than enough). Note: If you are adding small volumes (~1μl), be careful to mix the culture well. Diluting the plasmid
Preparing chemically competent cells
Materials Plate of cells to be made competent TSS buffer LB media Ice Glassware & Equipment Falcon tubes 500μl Eppendorf tubes, on ice 200ml conical flask 200μl pipetman or repeating
TOP10 chemically competent cells
Overview This protocol is a variant of the Hanahan protocol [1] using CCMB80 buffer for DH10B, TOP10 and MachI strains. It builds on Example 2 of the Bloom05 patent as well. This protocol has been tested on TOP10, MachI and BL21(DE3) cells
技术资料暂无技术资料 索取技术资料